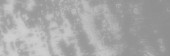

Słońce Panoramiczny Brudny Marmur. Złote Panoramiczne Tło. Szara farba artystyczna. Szary Panorama Lekki Marmur. Streszczenie Brudny szablon szary marmur tle. Szare orientalne tło. Nowoczesny brudny wzór.

Informacje o pliku:
| Numer pliku: | 0101547753530 |
| Typ pliku/format: | Zdjęcia ( JPG ) |
| Rozdzielczość: | 5298x757 (44,86x6,41 cm 300 dpi) |
| Kategorie: | |
| Autor: | Tirmandir |